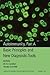
Autoimmunity, Part A: Basic...

|
Mosaic of Autoimmunity: The Novel Factors of Autoimmune Diseases
by
|
|

|
Autoimmunity, Part C: The Mosaic of Autoimmunity, Volume 1107
by
really liked it 4.00 avg rating — 1 rating
—
published
2007
|
|

|
Atherosclerosis and Autoimmunity
by
really liked it 4.00 avg rating — 1 rating
—
published
2001
—
2 editions
|
|

|
Autoimunita: Vnitřní nepřítel
by
really liked it 4.00 avg rating — 1 rating
|
|

|
The Antiphospholipid Syndrome II: Autoimmune Thrombosis
by
liked it 3.00 avg rating — 1 rating
—
published
2002
—
3 editions
|
|

|
Natural Autoantibodies
by
it was ok 2.00 avg rating — 1 rating
—
published
1992
|
|

|
Idiotypes in Medicine: Autoimmunity, Infection and Cancer
by
|
|

|
Idiotypes in Medicine: Autoimmunity, Infection and Cancer: Autoimmunity, Infection and Cancer
by
it was ok 2.00 avg rating — 1 rating
—
published
2013
|
|

|
The Israeli Fitness Strategy: A Complete Program of Diet and Exercise Based on the Training System of the Israel Defense Forces
by
it was ok 2.00 avg rating — 1 rating
|
|

|
Cancer and Autoimmunity
by
0.00 avg rating — 0 ratings
—
published
2000
—
2 editions
|
|

|
Autoimmune Disease Diagnosis: Systemic and Organ-specific Diseases
by
|
|

|
Autoimmunity, COVID-19, Post-COVID19 Syndrome and COVID-19 Vaccination
by
0.00 avg rating — 0 ratings
|
|

|
Immunotherapeutic Agents for SLE
by
|
|

|
Autoimmunity, COVID-19, Post-COVID19 Syndrome and COVID-19 Vaccination (Volume 1) (Future of Autoimmunity Research, Volume 1)
by
0.00 avg rating — 0 ratings
|
|

|
Familial Mediterranean Fever
by
0.00 avg rating — 0 ratings
|
|

|
Infection and Autoimmunity
by
0.00 avg rating — 0 ratings
—
published
2015
—
4 editions
|
|

|
The Decade of Autoimmunity
by
0.00 avg rating — 0 ratings
—
published
1999
—
2 editions
|
|

|
Autoantibodies
by
0.00 avg rating — 0 ratings
—
published
2006
—
5 editions
|
|

|
Contemporary Challenges in Autoimmunity, Volume 1173
by
0.00 avg rating — 0 ratings
—
published
2009
|
|

|
The Mosaic of Autoimmunity (Research Monographs in Immunology, 12)
by
0.00 avg rating — 0 ratings
—
published
1989
—
3 editions
|
|

|
Diagnostic Criteria in Autoimmune Diseases
by
0.00 avg rating — 0 ratings
—
published
2008
—
7 editions
|
|

|
Role of Microorganisms in Pathogenesis and Management of Autoimmune Diseases: Volume II: Kidney, Central Nervous System, Eye, Blood, Blood Vessels & Bowel
by
|
|

|
Role of Microorganisms in Pathogenesis and Management of Autoimmune Diseases: Volume II: Kidney, Central Nervous System, Eye, Blood, Blood Vessels & Bowel
by
0.00 avg rating — 0 ratings
|
|

|
Autoimmune Disorders: Adjuvants and Other Risk Factors in Pathogenesis
by
0.00 avg rating — 0 ratings
|
|

|
Role of Microorganisms in Pathogenesis and Management of Autoimmune Diseases: Volume II: Kidney, Central Nervous System, Eye, Blood, Blood Vessels & Bowel
by
0.00 avg rating — 0 ratings
|
|

|
Fibromyalgia Syndrome
by
|
|

|
Rheumatic Disease in Geriatrics: Diagnosis and Management
by
|
|

|
Role of Microorganisms in Pathogenesis and Management of Autoimmune Diseases: Volume I: Liver, Skin, Thyroid, Rheumatic & Myopathic Diseases
by
|
|

|
Autoimmune Disorders: Adjuvants and Other Risk Factors in Pathogenesis
by
0.00 avg rating — 0 ratings
|
|

|
Autoimmunity, Part A: Basic Principles and New Diagnostic Tools, Volume 1109
by
0.00 avg rating — 0 ratings
—
published
2007
|
|
* Note: these are all the books on Goodreads for this author. To add more books,
click here.